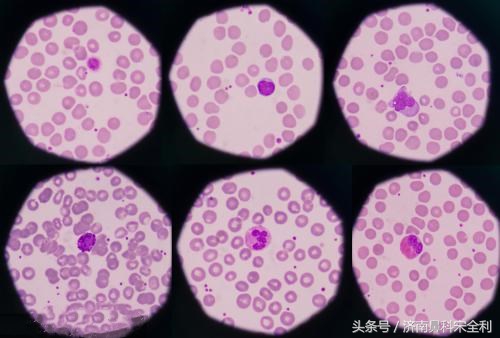
鼻息肉术后为什么会复发,鼻息肉手术后又复发了怎么处理

昨日,一位就诊的鼻息肉患者,让我对其深感同情。这位刘先生因双侧鼻塞、头痛、头胀为首要症状来医院就诊,经过鼻内镜检查之后发现其双侧的鼻腔内充满息肉样新生物,之后他的话令我为之一惊:我已经做过4次鼻息肉手术了,4次?很难想象一位鼻息肉患者会进行4次鼻息肉手术,这对于患者来讲是一个多么痛苦的折磨。

鼻息肉不断的生长,反复发作将其折磨的不成人样。鼻息肉究竟是如何产生的,为何他的鼻息肉进行了4次手术依旧会复发?要是鼻息肉再次复发了该怎么办?下面,请各位跟着我的思路走下去。
有人会问,为什么总是见鼻息肉反复发作,其发作的比例究竟有多高?
其实,国际上曾有一项研究,对伴有鼻息肉的鼻窦炎患者,第一次手术后随访12年,大约有80%的患者会复发,而其中大约有37%的患者需要再次进行手术。
而相较于国内,曾经抽样对387名鼻息肉患者进行了息肉切除手术,术后给予合理的药物治疗和密切随访。两年以后,45%的患者恢复的很好,鼻息肉没有再复发,不过另外的55%的鼻息肉患者在两年内陆续出现了复发的迹象。

鼻息肉复发率如此之高!究竟是什么原因造成了手术后鼻息肉的“卷土重来”?
1、鼻息肉患者鼻腔内的嗜酸粒细胞过高
在对以上387例做过鼻息肉手术的鼻息肉患者进行“复发组”和“非复发组”的分类之后,研究者发现,比较两者在显微镜下的“微观世界”有着很大的不同。复发的鼻息肉组织往往在显微镜下可见一种特殊的炎症细胞——嗜酸性粒细胞的大量繁殖。并且,随着该细胞的增多,患者复发的风险会相应增大,当鼻息肉中的嗜酸粒细胞占据所有炎症细胞的比值超过27%的时候,病人在两年内复发的风险概率会在95%以上。
显微镜下的嗜酸粒细胞
2、全身性因素:如严重过敏和哮喘等
鼻息肉是变态反应的结果,其实在哮喘和季节性鼻炎等呼吸道变态反应性疾病中,鼻息肉有着较高的发病率,但是在呼吸道感染性疾病中,比如说支气管扩张、肺结核中却是极为少见的。由于变态反应在鼻部多次发生,在组胺、白细胞三烯等化学介质的作用下,鼻黏膜小血管通透性增高,血浆渗出增加,这使得鼻黏膜极度水肿,受重力的影响而逐渐下垂,以致于形成鼻息肉。

3、局部因素,也是占比重最高的因素——鼻窦结构发育异常
这所谓的局部因素,其实也就是鼻窦发育的过程中,有些不利的结构因素。鼻窦中,存在很多细小的骨片,如果这些骨片发育过密,就会导致鼻腔的引流通道过窄,把窦腔封死,这以后,窦腔内部的分泌物就无法引流出来,于是会持续刺激黏膜的炎症状态。长此以往的黏膜炎症状态就会导致黏膜下结缔组织增生,这样就会形成鼻息肉。

4、手术操作不当
这其实也是一个无法忽视的原因所在。鼻息肉一旦形成以后,把窦腔的引流通道给堵得死死的,窦腔的炎症就无法向正常转归,这时候就需要医生来把窦腔息肉给切除。息肉切除其实就像“割韭菜”一样,只是切肉肯定是不行的,要把应该想到鼻腔引流功能的这些骨骼、小骨片安全地给彻底的切除干净,才能让大的窦腔(包括额窦、筛窦、蝶窦、上颌窦)引流通道彻底开放,这样可以创造一个良好的引流通道让炎症能够自行消退。

这种情况,即便再次遭遇急性上呼吸道感染的时候,窦腔内黏膜依然会发生炎症状态,但是只要把窦腔恰当的“开放”了,窦腔内的黏膜炎症就会自然的、像正常人一样痊愈。这也就是鼻息肉和慢性鼻窦炎发生的原因和两者可以治疗的原因。
那么,为什么有一部分人做了手术还会出现复发的情况呢?在排除全身因素之外,就要考虑这手术进行的是否如上一样的恰当了。

面对鼻息肉的复发,鼻息肉患者能做些什么?
鼻息肉的首要治疗目的就是达到和维持临床控制,通俗点来讲,就是使患者没有那些烦人的临床症状,从而拥有一个健康或基本健康的鼻腔。因此,为了达到这个治疗目标,需要进行包括手术在内的一系列长期的规范治疗,这就包括有术前、术中、术后,都要进行严格的药物治疗和定期随访。

鼻息肉手术之后,应该要注意哪些方面?
1、手术后的定期随访:患者要定期到医院检查术后的恢复状况,必要时需要进行术腔的清理,也就是将新生的肉芽或是囊破去除,以此来保证手术的效果,这种复诊的时间最多持续半年时间;
2、需要坚持局部用药:局部使用激素类药物可以减轻局部的炎症反应,从而降低鼻息肉的复发率。不过,需要注意的是,有一部分患者,即使采用上述的方法,仍有复发的可能性,就比如一些被称为“鼻息肉病”的患者。因此,这完全保证不复发是不现实的,但对于绝大部分人来说,鼻息肉手术的复发是基本可以控制住的;

3、工作或生活环境应该保持空气的新鲜;
4、平时,鼻腔内少用写薄荷或是冰片制剂;
5、忌辛辣、酒类等刺激性食品。
预防鼻息肉,不妨从平时做起
1、预防感冒:鼻息肉大多是由鼻炎引起的,而感冒又是导致鼻炎的重大因素,因此要积极防治感冒,加上今日已是“小雪”,所以要多增件衣服,切莫着凉。
2、增强身体抵抗能力:日常要加强体育锻炼,提高身体抵抗能力,每天晨起之时,最好要用冷水洗脸,以增强鼻部器官的耐寒性。

3、空气质量:尽量避免过长时间暴露在污染的环境之下,粉尘对于鼻、咽部的刺激也会引发鼻息肉。
4、注意用药:有鼻部疾病的患者,应当避免长期应用血管收缩剂,以免引起药物性鼻炎导致鼻息肉的发作。
鼻息肉手术在整个鼻息肉治疗过程中起着什么样的作用,鼻息肉复发,什么时候有再次进行鼻息肉手术的必要?
手术的目的只是通过开放关键区域并且保留鼻窦腔黏膜来重建鼻窦的通气和引流,所以说,对于复发性鼻息肉患者来讲,手术是整个治疗过程中的一个环节,或是我们可以称其为一个“新的开始”。手术发挥的作用表现在,一方面它能切除病变,另一方面是为了鼻窦开放、通畅引流以及帮助药物直达患处,奠定解剖学的基础,从而使得药物治疗事半功倍,以此达到最佳药用效果。

而当经过最大程度的药物治疗之后,鼻息肉患者的临床症状仍未得到改善,也就是不能达到临床控制的时候,此时才有进行手术的必要性。